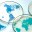

Intestinal Microbiology

Affiliation
The Institute of Experimental Medicine (IEM), Evolutionary Medicine department. Christian-Albrechts-University of Kiel & University Hospital Schleswig-Holstein, Germany
Research description
Prof Poyet is a microbiologist passionate about human health and evolution. She develops cutting-edge methodologies to deeply investigate the human gut microbiome genomic and functional diversity associated with health and disease. She is driven by a desire to leverage the therapeutic potential of the human microbiome for treating chronic diseases rising worldwide.
To counteract the unethical and truncated representation of human population diversity in microbiome science, she co-founded the Global Microbiome Conservancy (GMbC) whose mission is to biobank and characterize the representative human gut microbial biodiversity to advance microbiome knowledge and public health. Leveraging the GMbC biobank and clinical biobanks available at Kiel University, her research group is working in close collaboration with international researchers from low and middle income countries to perform in vitro, ex vivo, and bioinformatic assays to discover gut microbial functions associated with lifestyle and health/disease state.